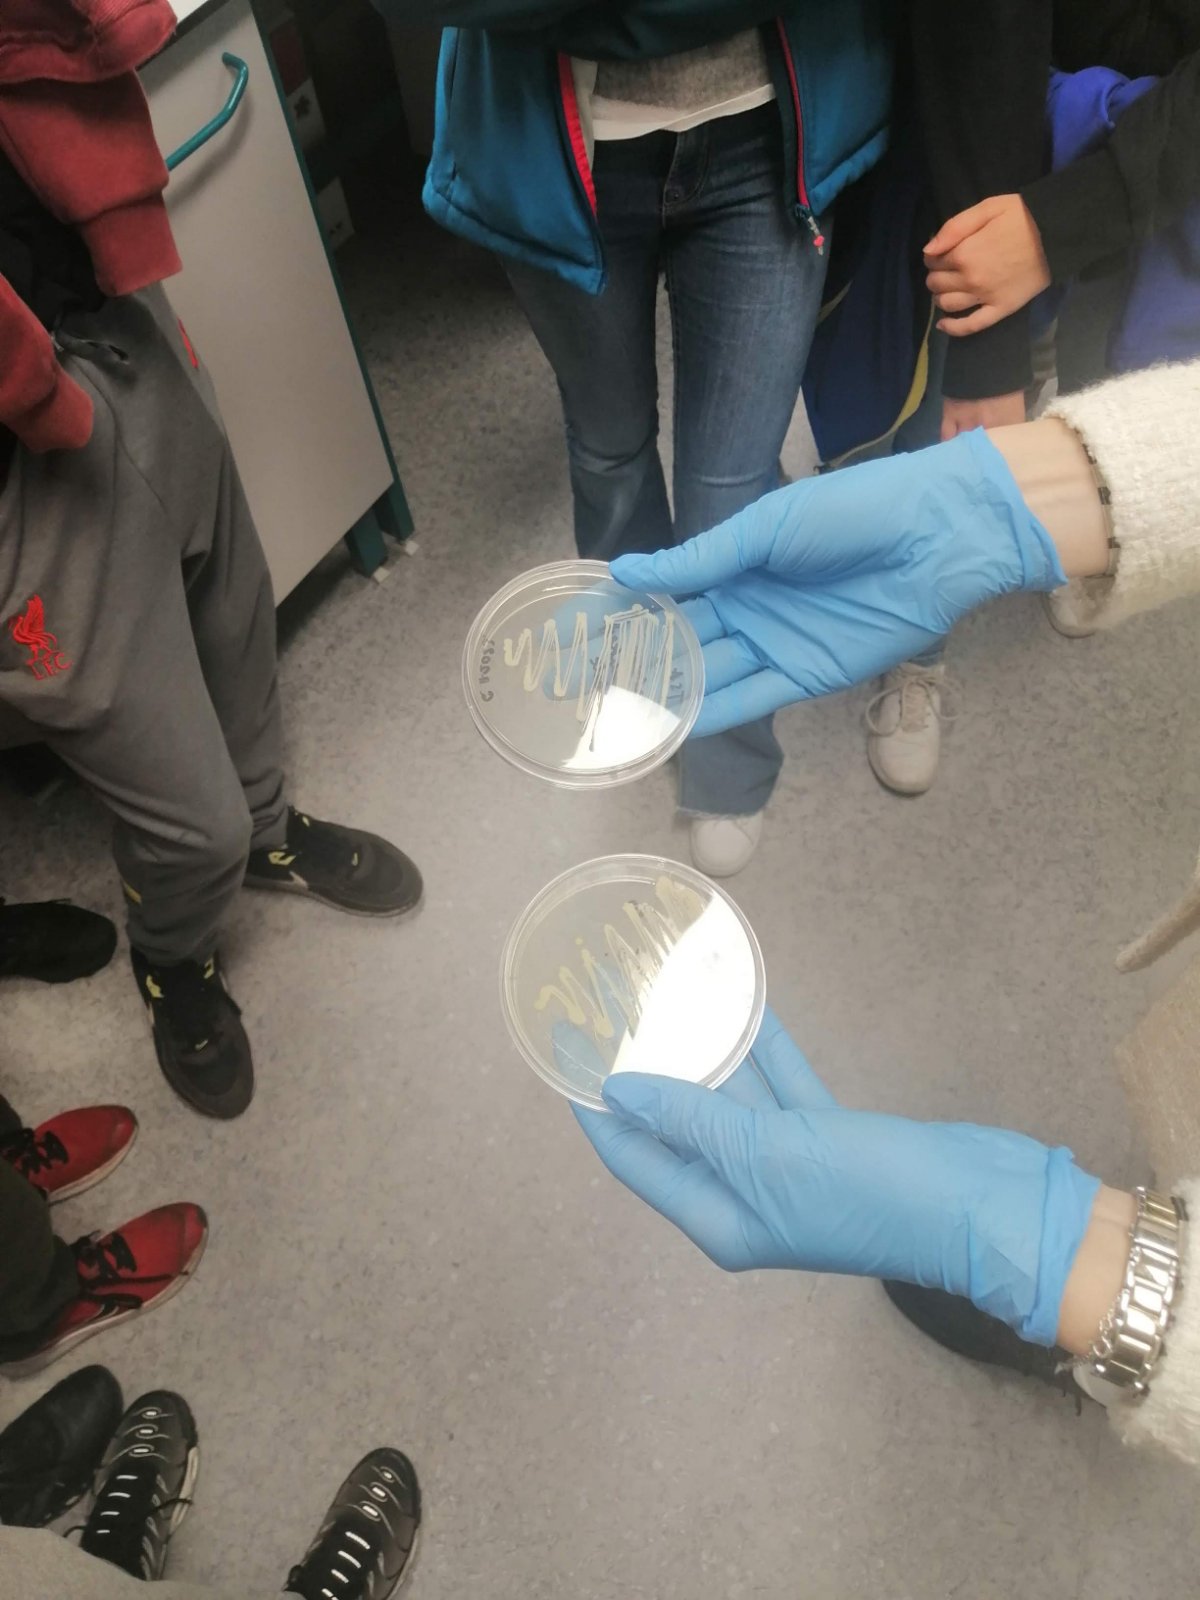

11. новембра, ученици наше школе су у склопу Слободне наставне активности Моја животна средина, са наставницом биологије Горданом Станојковић, посетили Институт "БиоСенс". Упознали су се са нанотехнологијом, како се прави култивисано месо од ћелија мишићног порекла, дружили се са роботом који је специјално дизајниран за потребе дигиталне пољопривреде, обишли радне просторије и најсавременије лабораторије за молекуларну биологију.